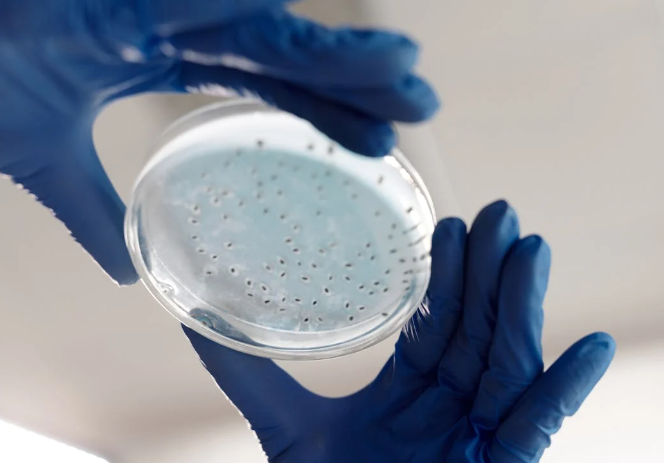

Researchers warn of rising antibiotic resistance in diarrheagenic E. coli, threatening treatment effectiveness.
A recent study out of China is raising concerns about the increasing resistance of diarrheagenic E. coli (DEC) to antibiotics. Over time, these bacteria have become harder to treat, making common cases of diarrhea more difficult to manage, especially in young children. The overuse and misuse of antibiotics are contributing to the problem, leading to the rise of strains that no longer respond to standard treatments. Researchers are calling for stricter regulations on antibiotic use and better monitoring to slow down this growing threat.
Between 2016 and 2022, scientists analyzed over 9,000 samples of DEC from people across 20 provinces in China. The findings were alarming: nearly 90% of the bacteria showed resistance to at least one antibiotic, while over 60% were resistant to multiple drugs. Some of the most commonly used antibiotics, such as ampicillin, were ineffective in more than two-thirds of cases. While some drugs, like imipenem, still worked in most cases, resistance to other treatments like cefoxitin and chloramphenicol was rising steadily. Researchers also noted that resistance patterns varied by region, highlighting the complexity of the issue and the need for localized strategies to address antibiotic resistance effectively.

One of the biggest concerns is that infants under the age of one showed the highest levels of resistance to multiple antibiotics. Since young children are already more vulnerable to dehydration and complications from diarrhea, this trend makes treating them even more challenging. The study found that Enteroaggregative E. coli (EAEC) was the most common strain, making up nearly half of the cases. These findings suggest that healthcare providers may need to rethink how they approach treatment, especially for infants and other high-risk groups. Parents and caregivers are also encouraged to be more aware of antibiotic resistance and to avoid unnecessary antibiotic use in children.
Dr. Yunchang Guo, the lead researcher, emphasized the need for continued surveillance and preventative measures. He stressed that reducing antibiotic overuse in both humans and livestock is essential to slowing the spread of resistant bacteria. The study also supports the idea of a “One Health” approach, which means tackling the problem from multiple angles—human health, animal health, and environmental factors—to limit the spread of drug-resistant bacteria. The role of food production and farming practices is also under scrutiny, as antibiotic use in livestock has been linked to increased resistance in bacteria that affect humans. By implementing stricter guidelines in agriculture and veterinary medicine, experts hope to reduce the spread of resistant strains from animals to people.
The results of this research provide important data for doctors and policymakers who are working to control antibiotic resistance. Without changes in how antibiotics are prescribed and used, more infections could become untreatable in the future. The study highlights the need for better guidelines, increased awareness, and more research into alternative treatments. Governments and public health organizations worldwide must take coordinated action to develop new antibiotics and treatment strategies. Education campaigns aimed at the public and healthcare professionals alike are necessary to ensure responsible antibiotic use. As resistant bacteria continue to spread, taking action now could help prevent a much bigger crisis in the years to come.
Sources:
Study highlights growing antibiotic resistance in diarrheagenic E. coli in China

Join the conversation!